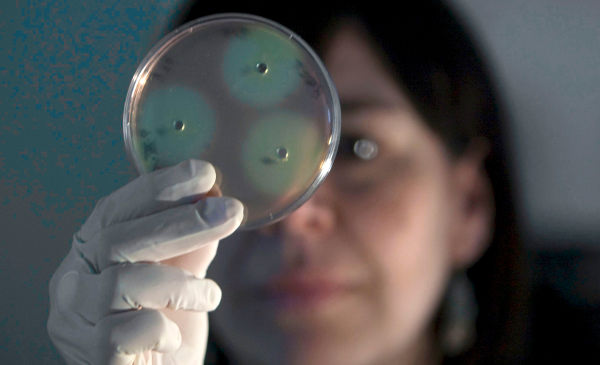

El término salmonela, que alude tanto a unas bacterias como a las enfermedades que estas producen, se escribe en español con una sola ele en la última sílaba y no con dos, y en minúscula.
En los medios de comunicación puede verse a menudo la grafía salmonella, con ll, como en «La salmonella, con un tratamiento adecuado, puede mejorar en menos de 48 horas», «Se identificó la presencia de salmonella en productos vencidos que salieron a la venta» o «Lo que exterminó a los pueblos originarios de México fue la salmonella».
El diccionario académico recoge la voz salmonela con dos significados: ‘bacteria anaerobia que contamina los alimentos, produciendo trastornos intestinales’ y ‘salmonelosis’, que a su vez es ‘infección por bacterias del género Salmonella’.
El nombre científico del género de las bacterias es Salmonella, escrito en cursiva y con mayúscula inicial, y a partir de él se forma el nombre común salmonela, en redonda y adaptado al español. El uso ha hecho que el nombre de la bacteria se aplique también a la enfermedad, tal y como se recoge en la obra citada, aunque conforme al Diccionario de términos médicos, de la Real Academia Nacional de Medicina de España, en textos especializados lo adecuado es mantener la distinción entre la bacteria (salmonela) y la enfermedad (salmonelosis).
Por ello, en los ejemplos anteriores, lo adecuado habría sido «La salmonela, con un tratamiento adecuado, puede mejorar en menos de 48 horas», «Se identificó la presencia de salmonela en productos vencidos que salieron a la venta» y «Lo que exterminó a los pueblos originarios de México fue la salmonela», aunque en el primero habría sido más preciso hablar de salmonelosis.